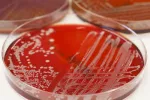
Tinción de Gram Tinción de Gram en el laboratorio

Cuándo se hace una tinción de Gram

La tinción de Gram está indicada en pacientes con neumonía
Por: David Saceda Corralo
Médico Interno Residente, especialista en Dermatología Medicoquirúrgica y Veneorología
Actualizado: 29 de julio de 2022
Se recomienda realizar una tinción de Gram en todas las situaciones en las que se quiera hacer una primera aproximación en la clasificación de las bacterias aisladas. Además de realizarla en estudios de investigación científica, también se realiza en hospitales y clínicas de todo el mundo ante estas enfermedades:
- Neumonías: se puede recoger una muestra de esputo sobre la que se realiza una tinción de Gram para identificar microorganismos responsables.
- Infección de orina: se puede utilizar la coloración de Gram en la orina con sospecha de infección. La muestra debe ser recogida con cuidado para no contaminarla con bacterias de la vagina o del prepucio.
- Uretritis: es la infección de transmisión sexual más frecuente y suele producir secreción a través de la uretra, que se recoge para realizar la tinción de Gram.
- Meningitis: la tinción de Gram teñirá las bacterias que estén infectando el líquido cefalorraquídeo.
- Exudado vaginal: aunque en la vagina hay multitud de bacterias, la tinción de Gram puede teñir todas ellas y ver la proporción de Gram positivas y Gram negativas. Así se diagnostican las vaginosis, tan frecuentes en las mujeres con menopausia.
- Abcesos: cuando se acumula pus en cualquier lugar se debe drenar y después planificar la antibioterapia si es necesaria, y para ello es muy útil saber qué tipo de bacteria es la causante del cuadro.
- Sepsis: en este caso la muestra recogida es la sangre; un tubo pequeño de cada brazo.
Creado: 10 de abril de 2014